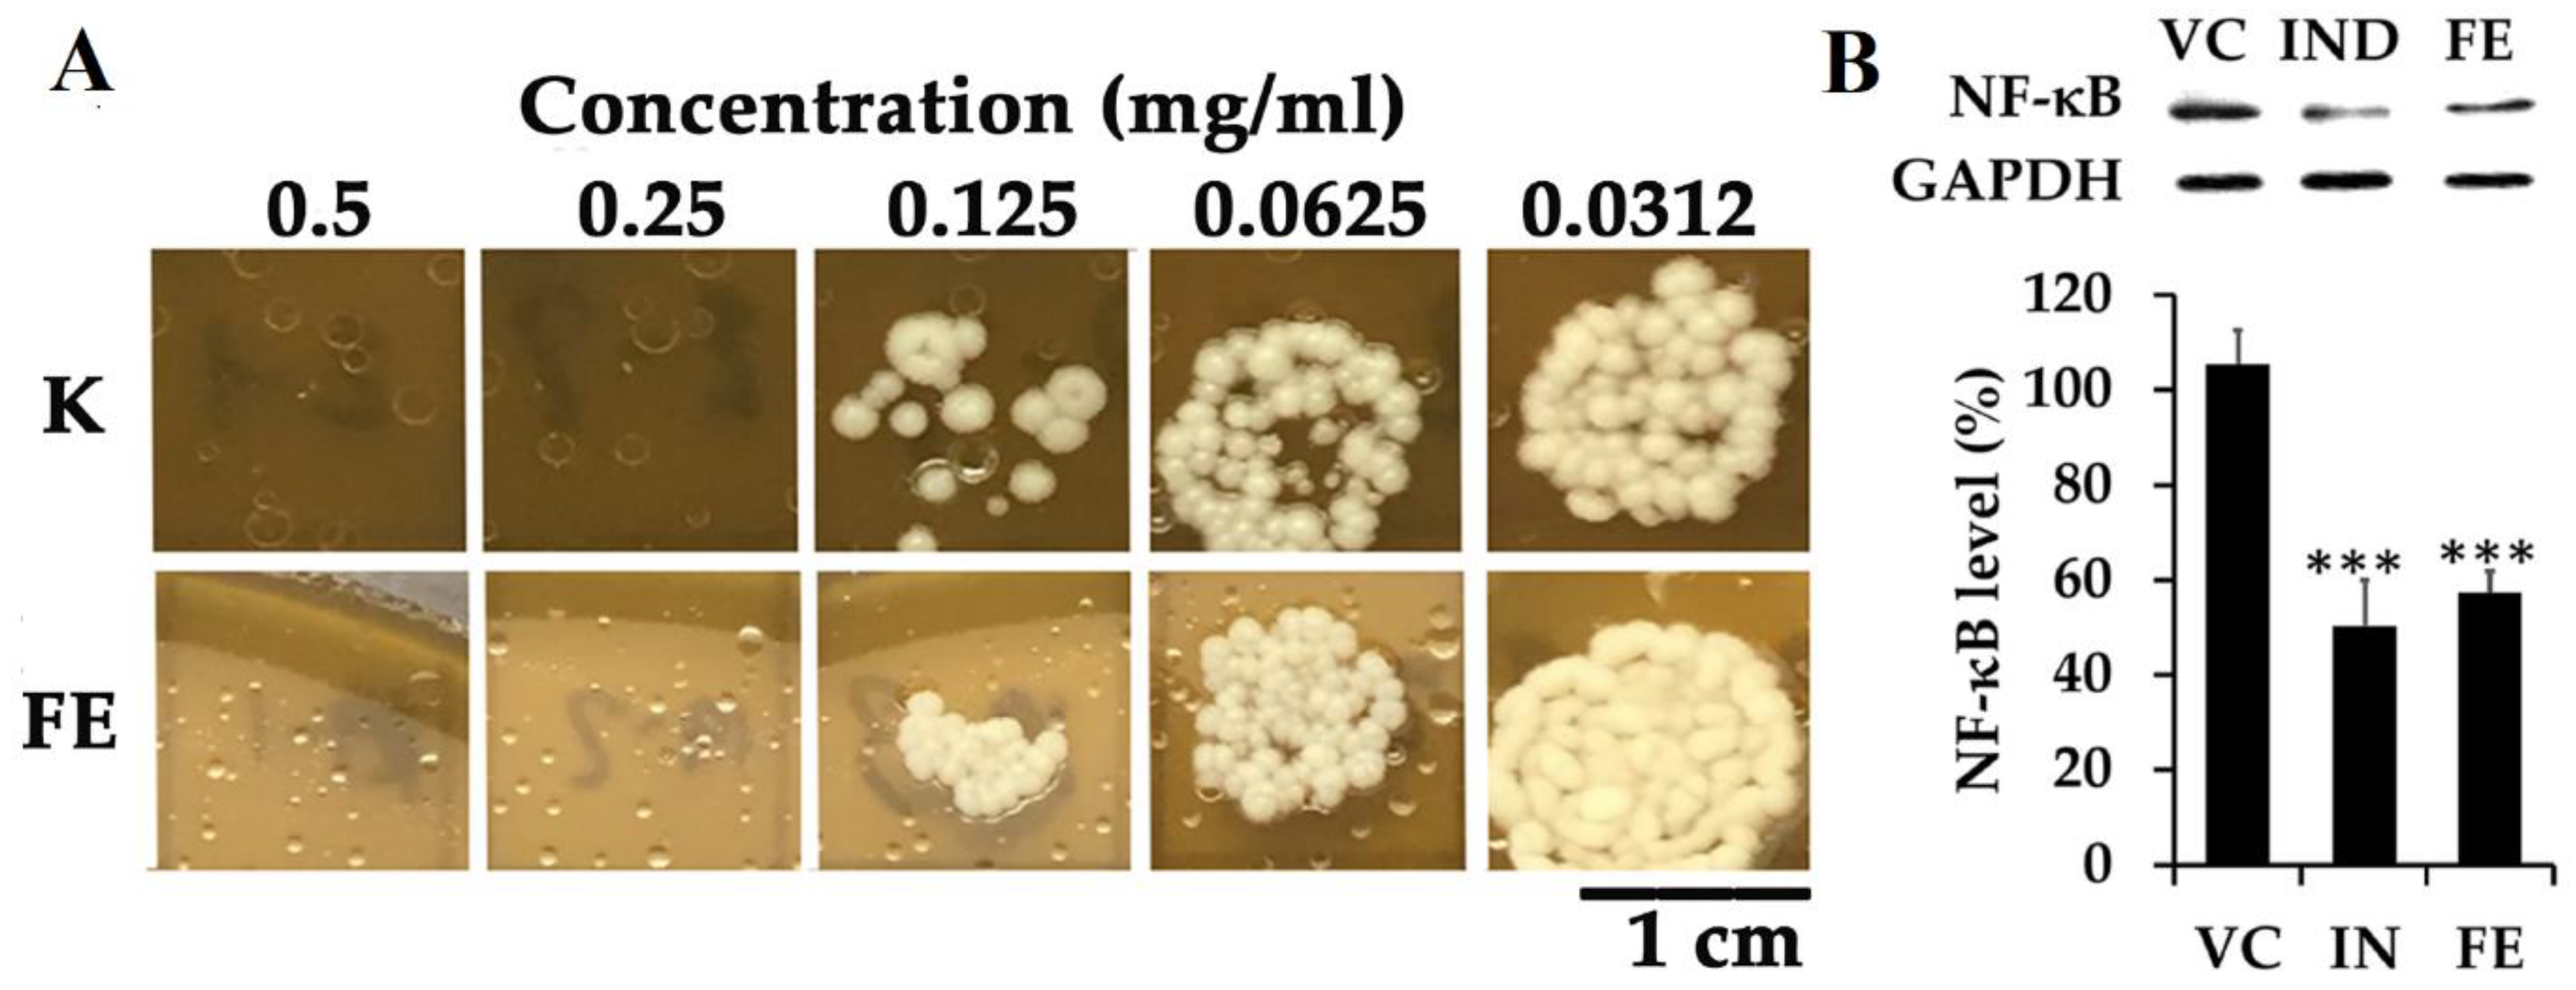

Anti-Malassezia Drug Candidates Based on Virulence Factors of Malassezia-Associated Diseases
Abstract
:1. Introduction
2. Malassezia Virulence Factors
2.1. Malassezia Cell Wall Resistance
2.2. Lipases, Phospholipases and Acid Sphingomyelinases
2.3. Melanin, ROS and Indoles
2.4. Hyphae Formation
2.5. Hydrophobicity and Biofilm Formation
3. Antifungal Drugs against Malassezia Species
3.1. Drugs Targeting Cell Wall and Membrane
3.1.1. Inhibition of the Cell Wall and Membrane Biosynthesis
3.1.2. Permeabilization of the Cell Membrane
Natural Compounds
Synthetic Compounds
3.2. Impact of Hydrophobicity in Drug Ability towards Malassezia spp.
3.3. Impacting Nuclear Aryl Hydrocarbon Receptors by AhR Antagonists
3.4. Targeting Enzymes Implied in Cell Survival
3.4.1. β-Class Carbonic Anhydrases
Synthetic Compounds
Natural Compounds
3.4.2. Quenching Secreted Lipases
3.5. Antioxidant Activities and ROS Attenuation
3.5.1. Extracts
3.5.2. Fatty Acids
3.5.3. Antimicrobial Peptides (AMPs)
3.6. Apoptosis Inducers
3.7. Targeting Hyphae Growth
3.8. Active Compounds without Known Biological Targets
3.8.1. Synthetic Anti-Malassezia Compounds
3.8.2. Bio-Inspired Compounds
3.8.3. Natural Compounds
4. Critical Review, Conclusions, and Perspectives
- Lipophilicity is the key. Indeed, natural active molecules are lipophilic, with logP ranging from 1.90 to 11.90, with a medium value around 3–4. Moreover, synthetic organic compounds also displayed high lipophilicity. This criterion can be adjusted by formulation if the drug is incorporated into lipidic nanoparticles, which favors skin penetration and decreases side-effects.
- Chemically speaking, two classes of molecules could be developed. These are (i) heteroatomic ones, including selenium or boron, with an adjusted HLB; and (ii) amphiphilic compounds with a high ability to disrupt the thick cell membrane.
- Biological targets remain underexploited. Based on the reported mode of action, it appears (Figure 29) that β-carbonic anhydrase inhibitors and antioxidant compounds are the most common. Drug candidates mainly target membranes. Three targets are under-valued in anti-Malassezia drug development, AhR antagonists, inhibitors of secreted lipase, and biofilm inhibitors.
- 4.
- Nature is a source of inspiration for the development of bio-inspired optimized drugs to selectively target Malassezia spp.
Author Contributions
Funding
Data Availability Statement
Conflicts of Interest
References
- Wu, G.; Zhao, H.; Li, C.; Rajapakse, M.P.; Wong, W.C.; Xu, J.; Saunders, C.W.; Reeder, N.L.; Reilman, R.A.; Scheynius, A.; et al. Genus-Wide Comparative Genomics of Malassezia Delineates Its Phylogeny, Physiology, and Niche Adaptation on Human Skin. PLoS Genet. 2015, 11, e1005614. [Google Scholar] [CrossRef] [PubMed]
- Crespo Erchiga, V.; Delgado Florencio, V. Malassezia species in skin diseases. Curr. Opin. Infect. Dis. 2002, 15, 133–142. [Google Scholar] [CrossRef] [PubMed]
- Theelen, B.; Cafarchia, C.; Gaitanis, G.; Bassukas, I.D.; Boekhout, T.; Dawson, T.L., Jr. Malassezia ecology, pathophysiology, and treatment. Med. Mycol. 2018, 56, S10–S25. [Google Scholar] [CrossRef] [PubMed]
- Gueho, E.; Boekhout, T.; Ashbee, H.R.; Guillot, J.; Van Belkum, A.; Faergemann, J. The role of Malassezia species in the ecology of human skin and as pathogens. Med. Mycol. 1998, 36, 220–229. [Google Scholar] [PubMed]
- Prohic, A.; Jovovic Sadikovic, T.; Krupalija-Fazlic, M.; Kuskunovic-Vlahovljak, S. Malassezia species in healthy skin and in dermatological conditions. Int. J. Dermatol. 2016, 55, 494–504. [Google Scholar] [CrossRef]
- Gupta, A.K.; Batra, R.; Bluhm, R.; Boekhout, T.; Dawson, T.L., Jr. Skin diseases associated with Malassezia species. J. Am. Acad. Dermatol. 2004, 51, 785–798. [Google Scholar] [CrossRef]
- Borda, L.J.; Wikramanayake, T.C. Seborrheic Dermatitis and Dandruff: A Comprehensive Review. J. Clin. Investig. Dermatol. 2015, 3, 10. [Google Scholar] [CrossRef]
- Waldroup, W.; Scheinfeld, N. Medicated shampoos for the treatment of seborrheic dermatitis. J. Drugs Dermatol. 2008, 7, 699–703. [Google Scholar]
- Saunte, D.M.L.; Gaitanis, G.; Hay, R.J. Malassezia-Associated Skin Diseases, the Use of Diagnostics and Treatment. Front. Cell Infect. Microbiol. 2020, 10, 112. [Google Scholar] [CrossRef]
- Sugita, T.; Suzuki, M.; Goto, S.; Nishikawa, A.; Hiruma, M.; Yamazaki, T.; Makimura, K. Quantitative analysis of the cutaneous Malassezia microbiota in 770 healthy Japanese by age and gender using a real-time PCR assay. Med. Mycol. 2010, 48, 229–233. [Google Scholar] [CrossRef]
- Jo, J.H.; Deming, C.; Kennedy, E.A.; Conlan, S.; Polley, E.C.; Ng, W.I.; Program, N.C.S.; Segre, J.A.; Kong, H.H. Diverse Human Skin Fungal Communities in Children Converge in Adulthood. J. Investig. Dermatol. 2016, 136, 2356–2363. [Google Scholar] [CrossRef] [PubMed]
- Gupta, A.K.; Kohli, Y. Prevalence of Malassezia species on various body sites in clinically healthy subjects representing different age groups. Med. Mycol. 2004, 42, 35–42. [Google Scholar] [CrossRef] [PubMed]
- Aspiroz, M.C.; Moreno, L.A.; Rubio, M.C. Taxonomy of Malassezia furfur: State of the art. Rev. Iberoam. Micol. 1997, 14, 147–149. [Google Scholar] [PubMed]
- Gueho, E.; Midgley, G.; Guillot, J. The genus Malassezia with description of four new species. Antonie van Leeuwenhoek 1996, 69, 337–355. [Google Scholar] [CrossRef]
- Leeming, J.P.; Notman, F.H.; Holland, K.T. The distribution and ecology of Malassezia furfur and cutaneous bacteria on human skin. J. Appl. Bacteriol. 1989, 67, 47–52. [Google Scholar] [CrossRef]
- Sugita, T.; Takashima, M.; Shinoda, T.; Suto, H.; Unno, T.; Tsuboi, R.; Ogawa, H.; Nishikawa, A. New yeast species, Malassezia dermatis, isolated from patients with atopic dermatitis. J. Clin. Microbiol. 2002, 40, 1363–1367. [Google Scholar] [CrossRef]
- Honnavar, P.; Prasad, G.S.; Ghosh, A.; Dogra, S.; Handa, S.; Rudramurthy, S.M. Malassezia arunalokei sp. nov., a Novel Yeast Species Isolated from Seborrheic Dermatitis Patients and Healthy Individuals from India. J. Clin. Microbiol. 2016, 54, 26–1834. [Google Scholar] [CrossRef]
- Marcon, M.J.; Powell, D.A. Human infections due to Malassezia spp. Clin. Microbiol. Rev. 1992, 5, 101–119. [Google Scholar] [CrossRef]
- Sugita, T.; Tajima, M.; Takashima, M.; Amaya, M.; Saito, M.; Tsuboi, R.; Nishikawa, A. A new yeast, Malassezia yamatoensis, isolated from a patient with seborrheic dermatitis, and its distribution in patients and healthy subjects. Microbiol. Immunol. 2004, 48, 579–583. [Google Scholar] [CrossRef]
- Sugita, T.; Takashima, M.; Kodama, M.; Tsuboi, R.; Nishikawa, A. Description of a new yeast species, Malassezia japonica, and its detection in patients with atopic dermatitis and healthy subjects. J. Clin. Microbiol. 2003, 41, 4695–4699. [Google Scholar] [CrossRef]
- Keddie, F.M.; Barajas, L. Quantitative ultrastructural variations between Pityrosporum ovale and P. orbiculare based on serial section electron microscopy. Int. J. Dermatol. 1972, 11, 40–48. [Google Scholar] [CrossRef] [PubMed]
- Ashbee, H.R.; Evans, E.G. Immunology of diseases associated with Malassezia species. Clin. Microbiol. Rev. 2002, 15, 21–57. [Google Scholar] [CrossRef]
- Thompson, E.; Colvin, J.R. Composition of the cell wall of Pityrosporum ovale (Bizzozero) Castellani and Chalmers. Can. J. Microbiol. 1970, 16, 263–265. [Google Scholar] [CrossRef] [PubMed]
- Mittag, H. Fine structural investigation of Malassezia furfur. II. The envelope of the yeast cells. Mycoses 1995, 38, 13–21. [Google Scholar] [CrossRef] [PubMed]
- Hort, W.; Mayser, P. Malassezia virulence determinants. Curr. Opin. Infect. Dis. 2011, 24, 100–105. [Google Scholar] [CrossRef] [PubMed]
- Ibrahim, A.S.; Mirbod, F.; Filler, S.G.; Banno, Y.; Cole, G.T.; Kitajima, Y.; Edwards, J.E., Jr.; Nozawa, Y.; Ghannoum, M.A. Evidence implicating phospholipase as a virulence factor of Candida albicans. Infect. Immun. 1995, 63, 1993–1998. [Google Scholar] [CrossRef]
- Stalhberger, T.; Simenel, C.; Clavaud, C.; Eijsink, V.G.; Jourdain, R.; Delepierre, M.; Latge, J.P.; Breton, L.; Fontaine, T. Chemical organization of the cell wall polysaccharide core of Malassezia restricta. J. Biol. Chem. 2014, 289, 12647–12656. [Google Scholar] [CrossRef]
- Xu, J.; Saunders, C.W.; Hu, P.; Grant, R.A.; Boekhout, T.; Kuramae, E.E.; Kronstad, J.W.; Deangelis, Y.M.; Reeder, N.L.; Johnstone, K.R.; et al. Dandruff-associated Malassezia genomes reveal convergent and divergent virulence traits shared with plant and human fungal pathogens. Proc. Natl. Acad. Sci. USA 2007, 104, 8730–8735. [Google Scholar] [CrossRef]
- Lan, D.; Xu, H.; Xu, J.; Dubin, G.; Liu, J.; Iqbal Khan, F.; Wang, Y. Malassezia globosa MgMDL2 lipase: Crystal structure and rational modification of substrate specificity. Biochem. Biophys. Res. Commun. 2017, 488, 259–265. [Google Scholar] [CrossRef]
- Mancianti, F.; Rum, A.; Nardoni, S.; Corazza, M. Extracellular enzymatic activity of Malassezia spp. isolates. Mycopathologia 2001, 149, 131–135. [Google Scholar] [CrossRef]
- Brunke, S.; Hube, B. MfLIP1, a gene encoding an extracellular lipase of the lipid-dependent fungus Malassezia furfur. Microbiology 2006, 152, 547–554. [Google Scholar] [CrossRef] [PubMed]
- Park, M.; Park, S.; Jung, W.H. Skin Commensal Fungus Malassezia and Its Lipases. J. Microbiol. Biotechnol. 2021, 31, 637–644. [Google Scholar] [CrossRef] [PubMed]
- Juntachai, W.; Oura, T.; Murayama, S.Y.; Kajiwara, S. The lipolytic enzymes activities of Malassezia species. Med. Mycol. 2009, 47, 477–484. [Google Scholar] [CrossRef]
- Nosanchuk, J.D.; Casadevall, A. The contribution of melanin to microbial pathogenesis. Cell. Microbiol. 2003, 5, 203–223. [Google Scholar] [CrossRef] [PubMed]
- Youngchim, S.; Nosanchuk, J.D.; Pornsuwan, S.; Kajiwara, S.; Vanittanakom, N. The role of L-DOPA on melanization and mycelial production in Malassezia furfur. PLoS ONE 2013, 8, e63764. [Google Scholar] [CrossRef] [PubMed]
- Gaitanis, G.; Chasapi, V.; Velegraki, A. Novel application of the masson-fontana stain for demonstrating Malassezia species melanin-like pigment production in vitro and in clinical specimens. J. Clin. Microbiol. 2005, 43, 4147–4151. [Google Scholar] [CrossRef]
- Spater, S.; Hipler, U.C.; Haustein, U.F.; Nenoff, P. Generation of reactive oxygen species in vitro by Malassezia yeasts. Hautarzt 2009, 60, 122–127. [Google Scholar]
- Mayser, P.; Wille, G.; Imkampe, A.; Thoma, W.; Arnold, N.; Monsees, T. Synthesis of fluorochromes and pigments in Malassezia furfur by use of tryptophan as the single nitrogen source. Mycoses 1998, 41, 265–271. [Google Scholar] [CrossRef]
- Magiatis, P.; Pappas, P.; Gaitanis, G.; Mexia, N.; Melliou, E.; Galanou, M.; Vlachos, C.; Stathopoulou, K.; Skaltsounis, A.L.; Marselos, M.; et al. Malassezia yeasts produce a collection of exceptionally potent activators of the Ah (dioxin) receptor detected in diseased human skin. J. Investig. Dermatol. 2013, 133, 2023–2030. [Google Scholar] [CrossRef]
- Gaitanis, G.; Magiatis, P.; Stathopoulou, K.; Bassukas, I.D.; Alexopoulos, E.C.; Velegraki, A.; Skaltsounis, A.L. AhR ligands, malassezin, and indolo[3,2-b]carbazole are selectively produced by Malassezia furfur strains isolated from seborrheic dermatitis. J. Investig. Dermatol. 2008, 128, 1620–1625. [Google Scholar] [CrossRef]
- Mexia, N.; Gaitanis, G.; Velegraki, A.; Soshilov, A.; Denison, M.S.; Magiatis, P. Pityriazepin and other potent AhR ligands isolated from Malassezia furfur yeast. Arch. Biochem. Biophys. 2015, 571, 16–20. [Google Scholar] [CrossRef] [PubMed]
- Sparber, F.; LeibundGut-Landmann, S. Host Responses to Malassezia spp. in the Mammalian Skin. Front. Immunol. 2017, 8, 1614. [Google Scholar] [CrossRef] [PubMed]
- Kramer, H.J.; Kessler, D.; Hipler, U.C.; Irlinger, B.; Hort, W.; Bodeker, R.H.; Steglich, W.; Mayser, P. Pityriarubins, novel highly selective inhibitors of respiratory burst from cultures of the yeast Malassezia furfur: Comparison with the bisindolylmaleimide arcyriarubin A. ChemBioChem 2005, 6, 2290–2297. [Google Scholar] [CrossRef] [PubMed]
- Tauchi, M.; Hida, A.; Negishi, T.; Katsuoka, F.; Noda, S.; Mimura, J.; Hosoya, T.; Yanaka, A.; Aburatani, H.; Fujii-Kuriyama, Y.; et al. Constitutive expression of aryl hydrocarbon receptor in keratinocytes causes inflammatory skin lesions. Mol. Cell. Biol. 2005, 25, 9360–9368. [Google Scholar] [CrossRef] [PubMed]
- Youngchim, S.; Nosanchuk, J.D.; Chongkae, S.; Vanittanokom, N. Ketoconazole inhibits Malassezia furfur morphogenesis in vitro under filamentation optimized conditions. Arch. Dermatol. Res. 2017, 309, 47–53. [Google Scholar] [CrossRef] [PubMed]
- McGinley, K.J.; Leyden, J.J.; Marples, R.R.; Kligman, A.M. Quantitative microbiology of the scalp in non-dandruff, dandruff, and seborrheic dermatitis. J. Investig. Dermatol. 1975, 64, 401–405. [Google Scholar] [CrossRef]
- Hazen, K.C.; Hazen, B.W. Hydrophobic surface protein masking by the opportunistic fungal pathogen Candida albicans. Infect. Immun. 1992, 60, 1499–1508. [Google Scholar] [CrossRef]
- Masuoka, J.; Hazen, K.C. Cell wall mannan and cell surface hydrophobicity in Candida albicans serotype A and B strains. Infect. Immun. 2004, 72, 6230–6236. [Google Scholar] [CrossRef]
- Angiolella, L.; Leone, C.; Rojas, F.; Mussin, J.; de Los Angeles Sosa, M.; Giusiano, G. Biofilm, adherence, and hydrophobicity as virulence factors in Malassezia furfur. Med. Mycol. 2018, 56, 110–116. [Google Scholar] [CrossRef]
- Pedrosa, A.F.; Lisboa, C.; Branco, J.; Almeida, A.C.; Mendes, C.; Pellevoisin, C.; Leite-Moreira, A.; Miranda, I.M.; Rodrigues, A.G. Malassezia colonisation on a reconstructed human epidermis: Imaging studies. Mycoses 2019, 62, 1194–1201. [Google Scholar] [CrossRef]
- Cui, X.; Wang, L.; Lü, Y.; Yue, C. Development and research progress of anti-drug resistant fungal drugs. J. Infect. Public Health 2022, 15, 986–1000. [Google Scholar] [CrossRef] [PubMed]
- Yamazaki, T.; Inagaki, Y.; Fujii, T.; Ohwada, J.; Tsukazaki, M.; Umeda, I.; Kobayashi, K.; Shimma, N.; Page, M.G.; Arisawa, M. In vitro activity of isavuconazole against 140 reference fungal strains and 165 clinically isolated yeasts from Japan. Int. J. Antimicrob. Agents 2010, 36, 324–331. [Google Scholar] [CrossRef] [PubMed]
- Uchida, K.; Nishiyama, Y.; Tanaka, T.; Yamaguchi, H. In vitro activity of novel imidazole antifungal agent NND-502 against Malassezia species. Int. J. Antimicrob. Agents 2003, 21, 234–238. [Google Scholar] [CrossRef] [PubMed]
- Wang, K.; Cheng, L.; Li, W.; Jiang, H.; Zhang, X.; Liu, S.; Huang, Y.; Qiang, M.; Dong, T.; Li, Y.; et al. Susceptibilities of Malassezia strains from pityriasis versicolor, Malassezia folliculitis and seborrheic dermatitis to antifungal drugs. Heliyon 2020, 6, e04203. [Google Scholar] [CrossRef]
- Miranda, K.C.; de Araujo, C.R.; Costa, C.R.; Passos, X.S.; de Fátima Lisboa Fernandes, O.; do Rosário Rodrigues Silva, M. Antifungal activities of azole agents against the Malassezia species. Int. J. Antimicrob. Agents 2007, 29, 281–284. [Google Scholar] [CrossRef]
- Cafarchia, C.; Figueredo, L.A.; Iatta, R.; Colao, V.; Montagna, M.T.; Otranto, D. In vitro evaluation of Malassezia pachydermatis susceptibility to azole compounds using E-test and CLSI microdilution methods. Med. Mycol. 2012, 50, 795–801. [Google Scholar] [CrossRef]
- Do, E.; Lee, H.G.; Park, M.; Cho, Y.J.; Kim, D.H.; Park, S.H.; Eun, D.; Park, T.; An, S.; Jung, W.H. Antifungal Mechanism of Action of Lauryl Betaine Against Skin-Associated Fungus Malassezia restricta. Mycobiology 2019, 47, 242–249. [Google Scholar] [CrossRef]
- Nimura, K.; Niwano, Y.; Ishiduka, S.; Fukumoto, R. Comparison of in vitro antifungal activities of topical antimycotics launched in 1990s in Japan. Int. J. Antimicrob. Agents 2001, 18, 173–178. [Google Scholar] [CrossRef]
- Galván, I.J.; Mir-Rashed, N.; Jessulat, M.; Atanya, M.; Golshani, A.; Durst, T.; Petit, P.; Amiguet, V.T.; Boekhout, T.; Summerbell, R.; et al. Antifungal and antioxidant activities of the phytomedicine pipsissewa, Chimaphila umbellata. Phytochemistry 2008, 69, 738–746. [Google Scholar] [CrossRef]
- Liao, S.; Yang, G.; Huang, S.; Li, B.; Li, A.; Kan, J. Chemical composition of Zanthoxylum schinifolium Siebold & Zucc. essential oil and evaluation of its antifungal activity and potential modes of action on Malassezia restricta. Ind. Crops Prod. 2022, 180, 114698. [Google Scholar] [CrossRef]
- Lee, W.; Hwang, J.S.; Lee, D.G. A novel antimicrobial peptide, scolopendin, from Scolopendra subspinipes mutilans and its microbicidal mechanism. Biochimie 2015, 118, 176–184. [Google Scholar] [CrossRef]
- Lee, J.; Lee, D.G. Antifungal properties of a peptide derived from the signal peptide of the HIV-1 regulatory protein, Rev. FEBS Lett. 2009, 583, 1544–1547. [Google Scholar] [CrossRef] [PubMed]
- Choi, H.; Kim, K.-H.; Lee, D.G. Antifungal activity of the cationic antimicrobial polymer-polyhexamethylene guanidine hydrochloride and its mode of action. Fungal Biol. 2017, 121, 53–60. [Google Scholar] [CrossRef] [PubMed]
- Salvio, R. The guanidinium unit in the catalysis of phosphoryl transfer reactions: From molecular spacers to nanostructured supports. Chem. Eur. J. 2015, 21, 10960–10971. [Google Scholar] [CrossRef]
- Savelli, C.; Salvio, R. Guanidine-based polymer brushes grafted onto silica nanoparticles as efficient artificial phosphodiesterases. Chem. Eur. J. 2015, 21, 5856–5863. [Google Scholar] [CrossRef] [PubMed]
- Luo, X.; Jiang, Z.; Zhang, N.; Yang, Z.; Zhou, Z. Interactions of Biocidal Polyhexamethylene Guanidine Hydrochloride and Its Analogs with POPC Model Membranes. Polymers 2017, 9, 517. [Google Scholar] [CrossRef] [PubMed]
- Uppu, D.; Samaddar, S.; Hoque, J.; Konai, M.M.; Krishnamoorthy, P.; Shome, B.R.; Haldar, J. Side chain degradable cationic-amphiphilic polymers with tunable hydrophobicity show in vivo activity. Biomacromolecules 2016, 17, 3094–3102. [Google Scholar] [CrossRef] [PubMed]
- King, A.; Chakrabarty, S.; Zhang, W.; Zeng, X.M.; Ohman, D.E.; Wood, L.F.; Abraham, S.; Rao, R.; Wynne, K.J. High antimicrobial effectiveness with low hemolytic and cytotoxic activity for PEG/Quaternary copolyoxetanes. Biomacromolecules 2014, 15, 456–467. [Google Scholar] [CrossRef]
- Vullo, D.; Del Prete, S.; Nocentini, A.; Osman, S.M.; AlOthman, Z.; Capasso, C.; Bozdag, M.; Carta, F.; Gratteri, P.; Supuran, C.T. Dithiocarbamates effectively inhibit the β-carbonic anhydrase from the dandruff-producing fungus Malassezia globosa. Bioorg. Med. Chem. 2017, 25, 1260–1265. [Google Scholar] [CrossRef]
- Zhang, S.; Song, W.; Wu, H.; Wang, J.; Wang, Y.; Zhang, Z.; Lv, H. Lecithins-Zein nanoparticles for antifungal treatment: Enhancement and prolongation of drug retention in skin with reduced toxicity. Int. J. Pharm. 2020, 590, 119894. [Google Scholar] [CrossRef]
- Ramzan, M.; Kaur, G.; Trehan, S.; Agrewala, J.N.; Michniak-Kohn, B.B.; Hussain, A.; Mahdi, W.A.; Gulati, J.S.; Kaur, I.P. Mechanistic evaluations of ketoconazole lipidic nanoparticles for improved efficacy, enhanced topical penetration, cellular uptake (L929 and J774A.1), and safety assessment: In vitro and in vivo studies. J. Drug Deliv. Sci. Technol. 2021, 65, 102743. [Google Scholar] [CrossRef]
- Limongi de Souza, R.; Barros Dantas, A.G.; de Oliveira Melo, C.; Motta Felacio, I.; Oliveira, E.E. Nanotechnology as a tool to improve the biological activity of carvacrol: A review. J. Drug Deliv. Sci. Technol. 2022, 76, 103834. [Google Scholar] [CrossRef]
- Rosa, C.G.; Sganzerla, W.G.; Maciel, M.V.O.B.; de Melo, A.P.Z.; da Rosa Almeida, A.; Ramos Nunes, M.; Bertoldi, F.C.; Manique Barreto, P.L. Development of poly (ethylene oxide) bioactive nanocomposite films functionalized with zein nanoparticles. Colloids Surf. A Physicochem. Eng. Asp. 2020, 586, 124268. [Google Scholar] [CrossRef]
- Krämer, H.J.; Podobinska, M.; Bartsch, A.; Battmann, A.; Thoma, W.; Bernd, A.; Kummer, W.; Irlinger, B.; Steglich, W.; Mayser, P. Malassezin, a novel agonist of the aryl hydrocarbon receptor from the yeast Malassezia furfur, induces apoptosis in primary human melanocytes. ChemBioChem 2005, 6, 860–865. [Google Scholar] [CrossRef]
- Janosik, T.; Rannug, A.; Rannug, U.; Wahlström, N.; Slätt, J.; Bergman, J. Chemistry and Properties of Indolocarbazoles. Chem. Rev. 2018, 118, 9058–9128. [Google Scholar] [CrossRef]
- Kallimanis, P.; Chinou, I.; Panagiotopoulou, A.; Soshilov, A.A.; He, G.; Denison, M.S.; Magiatis, P. Rosmarinus officinalis L. Leaf Extracts and Their Metabolites Inhibit the Aryl Hydrocarbon Receptor (AhR) Activation In Vitro and in Human Keratinocytes: Potential Impact on Inflammatory Skin Diseases and Skin Cancer. Molecules 2022, 27, 2499. [Google Scholar] [CrossRef]
- Supuran, C.T.; Capasso, C. A Highlight on the Inhibition of Fungal Carbonic Anhydrases as Drug Targets for the Antifungal Armamentarium. Int. J. Mol. Sci. 2021, 22, 4324. [Google Scholar] [CrossRef]
- Alterio, V.; Di Fiore, A.; D’Ambrosio, K.; Supuran, C.T.; De Simone, G. Multiple Binding Modes of Inhibitors to Carbonic Anhydrases: How to Design Specific Drugs Targeting 15 Different Isoforms? Chem. Rev. 2012, 112, 4421–4468. [Google Scholar] [CrossRef]
- Supuran, C.T. How many carbonic anhydrase inhibition mechanisms exist? J. Enzym. Inhib. Med. Chem. 2016, 31, 345–360. [Google Scholar] [CrossRef]
- Shinde, S.D.; Sakla, A.P.; Shankaraiah, N. An insight into medicinal attributes of dithiocarbamates: Bird’s eye view. Bioorg. Chem. 2020, 105, 104346. [Google Scholar] [CrossRef]
- Nocentini, A.; Vullo, D.; Bartolucci, G.; Supuran, C.T. N-Nitrosulfonamides: A new chemotype for carbonic anhydrase inhibition. Bioorg. Med. Chem. 2016, 24, 3612–3617. [Google Scholar] [CrossRef] [PubMed]
- Bua, S.; Osman, S.M.; AlOthman, Z.; Supuran, C.T.; Nocentini, A. Benzenesulfonamides incorporating nitrogenous bases show effective inhibition of β-carbonic anhydrases from the pathogenic fungi Cryptococcus neoformans, Candida glabrata and Malassezia globosa. Bioorg. Chem. 2019, 86, 39–43. [Google Scholar] [CrossRef]
- Estevez-Fregoso, E.; Farfán-García, E.D.; García-Coronel, I.H.; Martínez-Herrera, E.; Alatorre, A.; Scorei, R.I.; Soriano-Ursúa, M.A. Effects of boron-containing compounds in the fungal kingdom. J. Trace Elem. Med. Biol. 2021, 65, 126714. [Google Scholar] [CrossRef] [PubMed]
- Nocentini, A.; Cadoni, R.; Del Prete, S.; Capasso, C.; Dumy, P.; Gratteri, P.; Supuran, C.T.; Winum, J.Y. Benzoxaboroles as Efficient Inhibitors of the β-Carbonic Anhydrases from Pathogenic Fungi: Activity and Modeling Study. ACS Med. Chem. Lett. 2017, 8, 1194–1198. [Google Scholar] [CrossRef] [PubMed]
- Supuran, C.T. Bortezomib inhibits bacterial and fungal β-carbonic anhydrases. Bioorg. Med. Chem. 2016, 24, 4406–4409. [Google Scholar] [CrossRef]
- Angeli, A.; Velluzzi, A.; Selleri, S.; Capasso, C.; Spadini, C.; Iannarelli, M.; Cabassi, C.S.; Carta, F.; Supuran, C.T. Seleno Containing Compounds as Potent and Selective Antifungal Agents. ACS Infect. Dis. 2022, 8, 1905–1919. [Google Scholar] [CrossRef]
- Nocentini, A.; Bua, S.; Del Prete, S.; Heravi, Y.E.; Saboury, A.A.; Karioti, A.; Bilia, A.R.; Capasso, C.; Gratteri, P.; Supuran, C.T. Natural Polyphenols Selectively Inhibit β-Carbonic Anhydrase from the Dandruff-Producing Fungus Malassezia globosa: Activity and Modeling Studies. ChemMedChem 2018, 13, 816–823. [Google Scholar] [CrossRef]
- Entezari Heravi, Y.; Bua, S.; Nocentini, A.; Del Prete, S.; Saboury, A.A.; Sereshti, H.; Capasso, C.; Gratteri, P.; Supuran, C.T. Inhibition of Malassezia globosa carbonic anhydrase with phenols. Bioorg. Med. Chem. 2017, 25, 2577–2582. [Google Scholar] [CrossRef]
- Sivasankar, C.; Gayathri, S.; Bhaskar, J.P.; Krishnan, V.; Pandian, S.K. Evaluation of selected Indian medicinal plants for antagonistic potential against Malassezia spp. and the synergistic effect of embelin in combination with ketoconazole. Microb. Pathog. 2017, 110, 66–72. [Google Scholar] [CrossRef]
- Schlemmer, K.B.; Jesus, F.P.K.; Tondolo, J.S.M.; Weiblen, C.; Azevedo, M.I.; Machado, V.S.; Botton, S.A.; Alves, S.H.; Santurio, J.M. In vitro activity of carvacrol, cinnamaldehyde and thymol combined with antifungals against Malassezia pachydermatis. J. Mycol. Med. 2019, 29, 375–377. [Google Scholar] [CrossRef]
- Guo, S.; Huang, W.; Zhang, J.; Wang, Y. Novel inhibitor against Malassezia globosa LIP1 (SMG1), a potential anti-dandruff target. Bioorg. Med. Chem. Lett. 2015, 25, 3464–3467. [Google Scholar] [CrossRef]
- Chaiyana, W.; Punyoyai, C.; Sriyab, S.; Prommaban, A.; Sirilun, S.; Maitip, J.; Chantawannakul, P.; Neimkhum, W.; Anuchapreeda, S. Anti-Inflammatory and Antimicrobial Activities of Fermented Ocimum sanctum Linn. Extracts against Skin and Scalp Microorganisms. Chem. Biodivers. 2022, 9, e202100799. [Google Scholar] [CrossRef]
- Dembetembe, T.T.; Rademan, S.; Twilley, D.; Banda, G.W.; Masinga, L.; Lall, N.; Kritzinger, Q. Antimicrobial and cytotoxic effects of medicinal plants traditionally used for the treatment of sexually transmitted diseases. S. Afr. J. Bot. 2023, 154, 300–308. [Google Scholar] [CrossRef]
- Susano, P.; Silva, J.; Alves, C.; Martins, A.; Pinteus, S.; Gaspar, H.; Goettert, M.I.; Pedrosa, R. Mitigating the negative impacts of marine invasive species—Sargassum muticum—A key seaweed for skincare products development. Algal Res. 2022, 62, 102634. [Google Scholar] [CrossRef]
- Roopashree, P.G.; Shetty, S.S.; Kumari, N.S. Effect of medium chain fatty acid in human health and disease. J. Funct. Foods 2021, 87, 104724. [Google Scholar] [CrossRef]
- Augustin, K.; Khabbush, A.; Williams, S.; Eaton, S.; Orford, M.; Cross, J.H.; Heales, S.J.R.; Walker, M.C.; Williams, R.S.B. Mechanisms of action for the medium-chain triglyceride ketogenic diet in neurological and metabolic disorders. Lancet Neurol. 2018, 17, 84–93. [Google Scholar] [CrossRef]
- Lymperopoulos, A.; Suster, M.S.; Borges, J.I. Short-Chain Fatty Acid Receptors and Cardiovascular Function. Int. J. Mol. Sci. 2022, 23, 3303. [Google Scholar] [CrossRef] [PubMed]
- Rhimi, W.; Ben Salem, I.; Iatta, R.; Chaabane, H.; Saidi, M.; Boulila, A.; Cafarchia, C. Dittrichia viscosa L. leaves lipid extract: An unexploited source of essential fatty acids and tocopherols with antifungal and anti-inflammatory properties. Ind. Crops Prod. 2018, 113, 196–201. [Google Scholar] [CrossRef]
- Ferrucci, L.; Cherubini, A.; Bandinelli, S.; Bartali, B.; Corsi, A.; Lauretani, F.; Martin, A.; Andres-Lacueva, C.; Senin, U.; Guralnik, J.M. Relationship of plasma polyunsaturated fatty acids to circulating inflammatory markers. J. Clin. Endocrinol. Metab. 2006, 91, 439–446. [Google Scholar] [CrossRef] [PubMed]
- Pantzaris, M.C.; Loukaides, G.N.; Ntzani, E.E.; Patrikios, I.S. A novel oral nutraceutical formula of omega-3 and omega-6 fatty acids with vitamins (PLP10) in relapsing remitting multiple sclerosis: A randomised, double-blind, placebo-controlled proof-of-concept clinical trial. BMJ Open 2013, 3, e002170. [Google Scholar] [CrossRef]
- Nakae, H.; Endo, S.; Takakuwa, T.; Inada, K.; Yoshida, M. Relationship between alpha-tocopherol and polymorphonuclear leukocyte elastase in septic adult respiratory distress syndrome. Res. Commun. Mol. Pathol. Pharmacol. 1995, 89, 93–100. [Google Scholar]
- Huang, H.P.; Little, C.J.; Fixter, L.M. Effects of fatty acids on the growth and composition of Malassezia pachydermatis and their relevance to canine otitis externa. Res. Vet. Sci. 1993, 55, 119–123. [Google Scholar] [CrossRef] [PubMed]
- Ryu, S.; Choi, S.Y.; Acharya, S.; Chun, Y.J.; Gurley, C.; Park, Y.; Armstrong, C.A.; Song, P.I.; Kim, B.J. Antimicrobial and anti-inflammatory effects of Cecropin A(1-8)-Magainin2(1-12) hybrid peptide analog p5 against Malassezia furfur infection in human keratinocytes. J. Investig. Dermatol. 2011, 131, 1677–1683. [Google Scholar] [CrossRef] [PubMed]
- Carbone, M.; Irace, C.; Costagliola, F.; Castelluccio, F.; Villani, G.; Calado, G.; Padula, V.; Cimino, G.; Lucas Cervera, J.; Santamaria, R.; et al. A new cytotoxic tambjamine alkaloid from the Azorean nudibranch Tambja ceutae. Bioorg. Med. Chem. Lett. 2010, 20, 2668–2670. [Google Scholar] [CrossRef]
- Picott, K.J.; Deichert, J.A.; deKemp, E.M.; Schatte, G.; Sauriol, F.; Ross, A.C. Isolation and characterization of tambjamine MYP1, a macrocyclic tambjamine analogue from marine bacterium Pseudoalteromonas citrea. Med. Chem. Commun. 2019, 10, 478–483. [Google Scholar] [CrossRef] [PubMed]
- Manuel-Manresa, P.; Korrodi-Gregório, L.; Hernando, E.; Villanueva, A.; Martínez-García, D.; Rodilla, A.M.; Ramos, R.; Fardilha, M.; Moya, J.; Quesada, R.; et al. Novel Indole-based Tambjamine-Analogues Induce Apoptotic Lung Cancer Cell Death through p38 Mitogen-Activated Protein Kinase Activation. Mol. Cancer Ther. 2017, 16, 1224–1235. [Google Scholar] [CrossRef] [PubMed]
- Takaki, M.; Freire, V.F.; Nicacio, K.J.; Bertonha, A.F.; Nagashima, N.; Sarpong, R.; Padula, V.; Ferreira, A.G.; Berlinck, R.G.S. Metabolomics Reveals Minor Tambjamines in a Marine Invertebrate Food Chain. J. Nat. Prod. 2021, 84, 790–796. [Google Scholar] [CrossRef] [PubMed]
- Grenade, N.L.; Chiriac, D.S.; Pasternak, A.R.O.; Babulic, J.L.; Rowland, B.E.; Howe, G.W.; Ross, A.C. Discovery of a Tambjamine Gene Cluster in Streptomyces Suggests Convergent Evolution in Bipyrrole Natural Product Biosynthesis. ACS Chem. Biol. 2023, 18, 223–229. [Google Scholar] [CrossRef] [PubMed]
- Tangestani, M.; Broady, P.; Varsani, A. An investigation of antibacterial activity of New Zealand seaweed-associated marine bacteria. Future Microbiol. 2021, 16, 1167–1179. [Google Scholar] [CrossRef]
- Kancharla, P.; Kelly, J.X.; Reynolds, K.A. Synthesis and Structure-Activity Relationships of Tambjamines and B-Ring Functionalized Prodiginines as Potent Antimalarials. J. Med. Chem. 2015, 58, 7286–7309. [Google Scholar] [CrossRef]
- Kancharla, P.; Li, Y.; Yeluguri, M.; Dodean, R.A.; Reynolds, K.A.; Kelly, J.X. Total Synthesis and Antimalarial Activity of 2-(p-Hydroxybenzyl)-prodigiosins, Isoheptylprodigiosin, and Geometric Isomers of Tambjamine MYP1 Isolated from Marine Bacteria. J. Med. Chem. 2021, 64, 8739–8754. [Google Scholar] [CrossRef]
- Herraez, R.; Quesada, R.; Dahdah, N.; Vinas, M.; Vinuesa, T. Tambjamines and prodiginines: Biocidal activity against Trypanosoma cruzi. Pharmaceutics 2021, 13, 705. [Google Scholar] [CrossRef] [PubMed]
- Pinkerton, D.M.; Banwell, M.G.; Garson, M.J.; Kumar, N.; de Moraes, M.O.; Cavalcanti, B.C.; Barros, F.W.; Pessoa, C. Antimicrobial and cytotoxic activities of synthetically derived tambjamines C and E–J, BE-18591, and a related alkaloid from the marine bacterium Pseudoalteromonas tunicata. Chem. Biodivers. 2010, 7, 1311–1324. [Google Scholar] [CrossRef] [PubMed]
- Hernando, E.; Soto-Cerrato, V.; Cortes-Arroyo, S.; Perez-Tomas, R.; Quesada, R. Transmembrane anion transport and cytotoxicity of synthetic tambjamine analogs. Org. Biomol. Chem. 2014, 12, 1771–1778. [Google Scholar] [CrossRef] [PubMed]
- Knight, N.J.; Hernando, E.; Haynes, C.J.E.; Busschaert, N.; Clarke, H.J.; Takimoto, K.; Garcia-Valverde, M.; Frey, J.G.; Quesada, R.; Gale, P.A. QSAR analysis of substituent effects on tambjamine anion transporters. Chem. Sci. 2016, 7, 1600–1608. [Google Scholar] [CrossRef]
- Fiore, M.; Cossu, C.; Capurro, V.; Picco, C.; Ludovico, A.; Mielczarek, M.; Carreira-Barral, I.; Caci, E.; Baroni, D.; Quesada, R.; et al. Small molecule-facilitated anion transporters in cells for a novel therapeutic approach to cystic fibrosis. Brit. J. Pharmacol. 2019, 176, 1764–1779. [Google Scholar] [CrossRef]
- Fiore, M.; Garcia-Valverde, M.; Carreira-Barral, I.; Moran, O. The different anion transport capability of prodiginine- and tambjamine-like molecules. Eur. J. Pharmacol. 2020, 889, 173592. [Google Scholar] [CrossRef]
- Carreira-Barral, I.; Mielczarek, M.; Alonso-Carrillo, D.; Capurro, V.; Soto-Cerrato, V.; Perez Tomas, R.; Caci, E.; Garcia-Valverde, M.; Quesada, R. Click-tambjamines as efficient and tunable bioactive anion transporters. Chem. Commun. 2020, 56, 3218–3221. [Google Scholar] [CrossRef]
- Saggiomo, V.; Otto, S.; Marques, I.; Felix, V.; Torroba, T.; Quesada, R. The role of lipophilicity in transmembrane anion transport. Chem. Commun. 2012, 48, 5274–5276. [Google Scholar] [CrossRef]
- Lee, J.; Hwang, J.S.; Hwang, I.S.; Cho, J.; Lee, E.; Kim, Y.; Lee, D.G. Coprisin-induced antifungal effects in Candida albicans correlate with apoptotic mechanisms. Free Radic. Biol. Med. 2012, 52, 2302–2311. [Google Scholar] [CrossRef]
- Laokor, N.; Juntachai, W. Exploring the antifungal activity and mechanism of action of Zingiberaceae rhizome extracts against Malassezia furfur. J. Ethnopharmacol. 2021, 279, 114354. [Google Scholar] [CrossRef] [PubMed]
- Thulam, V.K.; Kotte, S.C.B.; Kumar, H.S.; Murali, P.M.; Mukkanti, K.; Mainker, P.S. A novel and efficient method for N-acylation of sulfonamides and carbamates: Their biological evaluation towards anti Malassezia activity, J. Pharm. Res. 2013, 7, 195–199. [Google Scholar] [CrossRef]
- Trifonov, L.; Chumin, K.; Gvirtz, R.; Afri, M.; Korshin, E.E.; Cohen, G.; Gruzman, A. Novel sulfamoylbenzoates as antifungal agents against Malassezia furfur. Mendeleev Commun. 2020, 30, 709–711. [Google Scholar] [CrossRef]
- Sathishkumar, P.; Preethi, J.; Vijayan, R.; Mohd Yusoff, A.R.; Ameen, F.; Suresh, S.; Balagurunathan, R.; Palvannan, T. Anti-acne, anti-dandruff and anti-breast cancer efficacy of green synthesised silver nanoparticles using Coriandrum sativum leaf extract. J. Photochem. Photobiol. B 2016, 163, 69–76. [Google Scholar] [CrossRef]
- Rao, K.J.; Paria, S. Anti-Malassezia furfur activity of natural surfactant mediated in situ silver nanoparticles for a better antidandruff shampoo formulation. RSC Adv. 2016, 6, 11064–11069. [Google Scholar] [CrossRef]
- Marena, G.D.; Ramos, M.A.D.S.; Carvalho, G.C.; Junior, J.A.P.; Resende, F.A.; Corrêa, I.; Ono, G.Y.B.; Sousa Araujo, V.H.; de Camargo, B.A.F.; Bauab, T.M.; et al. Natural product-based nanomedicine applied to fungal infection treatment: A review of the last 4 years. Phytother. Res. 2022, 36, 2710–2745. [Google Scholar] [CrossRef]
- Khosravi, A.R.; Shokri, H.; Fahimirad, S. Efficacy of medicinal essential oils against pathogenic Malassezia sp. isolates. J. Mycol. Med. 2016, 26, 28–34. [Google Scholar] [CrossRef]
- Rajput, M.; Kumar, N. Medicinal plants: A potential source of novel bioactive compounds showing antimicrobial efficacy against pathogens infecting hair and scalp. Gene Rep. 2020, 21, 100879. [Google Scholar] [CrossRef]
- Zhan, J.; He, F.; Cai, H.; Wu, M.; Xiao, Y.; Xiang, F.; Yang, Y.; Ye, C.; Wang, S.; Li, S. Composition and antifungal mechanism of essential oil from Chrysanthemum morifolium cv. Fubaiju. J. Funct. Foods 2021, 87, 104746. [Google Scholar] [CrossRef]
- Santomauro, F.; Donato, R.; Pini, G.; Sacco, C.; Ascrizzi, R.; Bilia, A.R. Liquid and Vapor-Phase Activity of Artemisia annua Essential Oil against Pathogenic Malassezia spp. Planta Med. 2018, 84, 160–167. [Google Scholar] [CrossRef]
- Adam, K.; Sivropoulou, A.; Kokkini, S.; Lanaras, T.; Arsenakis, M. Antifungal Activities of Origanumvulgare subsp. hirtum, Mentha spicata, Lavandula angustifolia, and Salvia fruticosa Essential Oils against Human Pathogenic Fungi. J. Agric. Food Chem. 1998, 46, 1739–1745. [Google Scholar] [CrossRef]
- Chee, H.Y.; Lee, M.H. In vitro Activity of Celery Essential Oil against Malassezia furfur. Mycobiology 2009, 37, 67–68. [Google Scholar] [CrossRef]
- Rukayadi, Y.; Diantini, A.; Lestari, K. Antifungal activity of methanolic extract of Usnea sp. against Malassezia furfur. Bionatura 2012, 14, 31–37. [Google Scholar]
- Sepahvand, A.; Studzinska-Sroka, E.; Ramak, P.; Karimian, V. Usnea sp.: Antimicrobial potential, bioactive compounds, ethnopharmacological uses and other pharmacological properties; a review article. J. Ethnopharm. 2021, 268, 113656. [Google Scholar] [CrossRef] [PubMed]
- Cardoso, R.L.; Maboni, F.; Machado, G.; Alves, S.H.; de Vargas, A.C. Antimicrobial activity of propolis extract against Staphylococcus coagulase positive and Malassezia pachydermatis of canine otitis. Vet. Microbiol. 2010, 142, 432–434. [Google Scholar] [CrossRef] [PubMed]
- Park, D.; Shin, K.; Choi, Y.; Guo, H.; Cha, Y.; Kim, S.H.; Han, N.S.; Joo, S.S.; Choi, J.K.; Lee, Y.B.; et al. Antimicrobial activities of ethanol and butanol fractions of white rose petal extract. Regul. Toxicol. Pharmacol. 2016, 76, 57–62. [Google Scholar] [CrossRef] [PubMed]
- Naeini, A.R.; Nazeri, M.; Shokri, H. Antifungal activity of Zataria multiflora, Pelargonium graveolens and Cuminum cyminum essential oils towards three species of Malassezia isolated from patients with pityriasis versicolor. J. Mycol. Med. 2011, 21, 87–91. [Google Scholar] [CrossRef]
- Donato, R.; Sacco, C.; Pini, G.; Bilia, A.R. Antifungal activity of different essential oils against Malassezia pathogenic species. J. Ethnopharmacol. 2020, 249, 112376. [Google Scholar] [CrossRef]
- Pooja, A.; Arun, N.; Maninder, K. Screening of plant essential oils for antifungal activity against Malassezia furfur. Int. J. Pharm. Pharm. Sci. 2013, 5, 37–39. [Google Scholar]
- Shahi, S.K.; Shahi, M.P.; Prakash, D. Syzygium aromaticum: Potent antidandruff agent with thermo-tolerance, quick killing action and long shelf life. Indo Am. J. Pharm. Res. 2015, 5, 795–802. [Google Scholar]
- Pinto, E.; Gonçalves, M.J.; Cavaleiro, C.; Salgueiro, L. Antifungal activity of Thapsia villosa essential oil against Candida, Cryptococcus, Malassezia, Aspergillus and Dermatophyte species. Molecules 2017, 22, 1595. [Google Scholar] [CrossRef] [PubMed]
- Guetat, A.; Boulila, A.; Boussaid, M. Phytochemical profile and biological activities of Deverra tortuosa (Desf.) DC.: A desert aromatic shrub widespread in Northern Region of Saudi Arabia. Nat. Prod. Res. 2019, 33, 2708–2713. [Google Scholar] [CrossRef] [PubMed]
- Vinciguerra, V.; Rojas, F.; Tedesco, V.; Giusiano, G.; Angiolella, L. Chemical characterization and antifungal activity of Origanum vulgare, Thymus vulgaris essential oils and carvacrol against Malassezia furfur. Nat. Prod. Res. 2019, 33, 3273–3277. [Google Scholar] [CrossRef] [PubMed]
- Barac, A.; Donadu, M.; Usai, D.; Spiric, V.T.; Mazzarello, V.; Zanetti, S.; Rubino, S. Antifungal activity of Myrtus communis against Malassezia sp. isolated from the skin of patients with P. versicolor. Infection 2018, 46, 253–257. [Google Scholar] [CrossRef]
- Kowalski, R. Antimicrobial activity of essential oils and extracts of rosinweed (Silphium trifoliatum and Silphium integrifolium) plants used by the American Indians. Flavour Fragr. J. 2008, 23, 426–433. [Google Scholar] [CrossRef]
- Onlom, C.; Khanthawong, S.; Waranuch, N.; Ingkaninan, K. In vitro anti-Malassezia activity and potential use in anti-dandruff formulation of Asparagus racemosus. Int. J. Cosmet. Sci. 2014, 36, 74–78. [Google Scholar] [CrossRef]
- Saravana Kumar, P.; Duraipandiyan, V.; Ignacimuthu, S. Isolation, screening and partial purification of antimicrobial antibiotics from soil Streptomyces sp. SCA 7. Kaohsiung J. Med. Sci. 2014, 30, 435–446. [Google Scholar] [CrossRef]
- Ho, J.-C. Antimicrobial, Mosquito Larvicidal and Antioxidant Properties of the Leaf and Rhizome of Hedychium coronarium. J. Chin. Chem. Soc. 2011, 58, 563–567. [Google Scholar] [CrossRef]
- Ho, J.-C. Chemical Composition and Bioactivity of Essential Oil of Seed and Leaf from Alpinia speciosa Grown in Taiwan. J. Chin. Chem. Soc. 2010, 57, 758–763. [Google Scholar] [CrossRef]
- Filip, R.; Davicino, R.; Anesini, C. Antifungal Activity of the Aqueous Extract of Ilex paraguariensis Against Malassezia furfur. Phytother. Res. 2010, 24, 715–719. [Google Scholar] [CrossRef]
- Lee, H.H.; Ahn, J.H.; Kwon, A.R.; Lee, E.S.; Kwak, J.H.; Min, Y.H. Chemical composition and antimicrobial activity of the essential oil of apricot seed. Phytother. Res. 2014, 28, 1867–1872. [Google Scholar] [CrossRef] [PubMed]
- Simonetti, G.; D’Auria, F.D.; Mulinacci, N.; Innocenti, M.; Antonacci, D.; Angiolella, L.; Santamaria, A.R.; Valletta, A.; Donati, L.; Pasqua, G. Anti-Dermatophyte and Anti-Malassezia Activity of Extracts Rich in Polymeric Flavan-3-ols Obtained from Vitis vinifera Seeds. Phytother. Res. 2017, 31, 124–131. [Google Scholar] [CrossRef] [PubMed]

| Malassezia Species | References |
|---|---|
| M. restricta | [13] |
| M. globosa | [14] |
| M. furfur | [15] |
| M. dermatis | [16] |
| M. arunalokei | [17] |
| M. slooffiae | [14] |
| M. sympodialis | [18] |
| M. obtusa | [13] |
| M. yamatoensis | [19] |
| M. japonica | [20] |
| Biological Target | Active Compounds |
|---|---|
| Fungal ergosterol synthesis inhibitors | Azoles (ketoconazole, itraconazole, fluconazole, voriconazole, posaconazole…) |
| Squalene epoxidase inhibitors | Morpholines: amorolfine |
| Allyamines: terbinafine, butenafine | |
| Ergosterol disruptors (membrane permeabilization) | Polyenes antibiotics: amphotericin B or nystatin |
| Glucan synthesis Inhibitors | Echinocandins, caspofungine, micafungine, anidulafungin |
| Chitin synthesis inhibitors | Nikkomycin, Polyoxins |
| Samples | M. furfur 133 | M. furfur 656 | M. furfur 6000 | M. furfur 7966 | ||||
|---|---|---|---|---|---|---|---|---|
| MIC50 | MFCs | MIC50 | MFCs | MIC50 | MFCs | MIC50 | MFCs | |
 Ketoconazole | 0.0078 | 0.0078 | 0.25 | 0.25 | 0.0625 | 0.0625 | 0.125 | 0.125 |
 Eugenol (main component of FE) | 0.125 | 0.125 | 0.25 | 0.25 | 0.125 | 0.5 | 0.125 | 0.5 |
| Entry |
ZOI *
(mm) |
Origanum vulgare
subsp. hirtum |
Mentha
spicata |
Lavandula
angustifolia |
Salvia
fruticose | |
|---|---|---|---|---|---|---|
| 1 | Thymol | 19 | 45.22 | - | - | 0.03 |
| 2 | Carvacrol | 15 | 33.05 | - | - | - |
| 3 | Carvone | 7 | - | 59.12 | - | - |
| 4 | dihydrocarveol | 9 | - | 6.87 | - | - |
| 5 | 1,8-cineole | 2 | 0.21 | 5.42 | 13.10 | 43.10 |
| 6 | Camphor | 2 | - | - | 5.50 | 18.34 |
| 7 | linalool | 0 | 0.18 | 0.06 | 20.18 | 0.12 |
| 8 | p-cymene | 1 | 7.35 | - | 0.09 | 0.93 |
| 9 | γ-terpinene | 1 | 5.54 | 0.04 | 0.07 | 0.09 |
| 10 | Linalyl acetate | 0 | - | - | 18.60 | 0.07 |
| 11 | Lavandulyl acetate | ND ** | - | - | 16.01 | - |
| 12 | limonene | 0 | 1.21 | 5.02 | 0.25 | 1.50 |
| 13 | Essential oil ZOI (mm) | 21 | 0 | 3.5 | 0 | |
 Zataria multiflora |  Pelargonium graveolens |  Cuminum cyminum | |
 |  |  | |
| Mean ZOI (mm) | 28.1 | 26.1 | 48.3 |
| Lower ZOI (mm) | 20 | 10 | 30 |
| Higher ZOI (mm) | >50 | >50 | >50 |
| Resource | Main Chemical Components | MIC | Reference | |
|---|---|---|---|---|
 | Cinnamomun zeylanicum Blume |  | 32 µg/mL | [139] |
 | Ocimum kilimandscharicum Gürke |  | 128 µg/mL | |
 | Malaleuca leucadendrun (L.) L. |  | 64 µg/mL | |
 | Syzygium aromaticum (L.) |  | 0.625 µL/mL | [140] |
 | Thapsia villosa (L.) |  | 2.5 µL/mL | [141] |
 | Deverra tortuosa subsp. arabica Chrtek, flowers |  | 5.0 µL/mL | [142] |
| Deverra tortuosa subsp. arabica Chrtek, stem | 8.0 µL/mL | |||
 | Origanum vulgare L. |  | 780 µg/mL | [143] |
 | Thymus vulgaris L. |  | 920 µg/mL | |
| M. furfur | M. sympodialis | M. slooffiae | M. globosa | M.obtusa | M. nana | M. restricta | ||||
|---|---|---|---|---|---|---|---|---|---|---|
| Bioresource | Main Chemical Components | MIC (µg/mL or *µL/mL) | Reference | |||||||
 | Zataria multiflora Boiss. |  | 35 | 30 | 80 | 50 | 60 | 30 | 40 | [127] |
 | Thymus kotschyanus Boiss. | 60 | 60 | 80 | 80 | 80 | 30 | 110 | ||
 | Mentha spicata L. |  | 125 | 100 | 100 | 250 | 85 | 65 | 85 | |
 | Artemisia sieberi Besser |  | 250 | 85 | 150 | 50 | 155 | 110 | 100 | |
 | Salvia rosmarinus Schleid. |  | 260 | 250 | 420 | 410 | 850 | 100 | 350 | |
 | Heracleum persicum Desf. ex Fisch. |  | 125 | 250 | 480 | 250 | 560 | 75 | 320 | |
 | Myrtus communis L. |  | 31 * | 62 | 31 | 31 | 62 | - | 125 | [144] |
Disclaimer/Publisher’s Note: The statements, opinions and data contained in all publications are solely those of the individual author(s) and contributor(s) and not of MDPI and/or the editor(s). MDPI and/or the editor(s) disclaim responsibility for any injury to people or property resulting from any ideas, methods, instructions or products referred to in the content. |
© 2023 by the authors. Licensee MDPI, Basel, Switzerland. This article is an open access article distributed under the terms and conditions of the Creative Commons Attribution (CC BY) license (https://creativecommons.org/licenses/by/4.0/).
Share and Cite
Billamboz, M.; Jawhara, S. Anti-Malassezia Drug Candidates Based on Virulence Factors of Malassezia-Associated Diseases. Microorganisms 2023, 11, 2599. https://doi.org/10.3390/microorganisms11102599
Billamboz M, Jawhara S. Anti-Malassezia Drug Candidates Based on Virulence Factors of Malassezia-Associated Diseases. Microorganisms. 2023; 11(10):2599. https://doi.org/10.3390/microorganisms11102599
Chicago/Turabian StyleBillamboz, Muriel, and Samir Jawhara. 2023. "Anti-Malassezia Drug Candidates Based on Virulence Factors of Malassezia-Associated Diseases" Microorganisms 11, no. 10: 2599. https://doi.org/10.3390/microorganisms11102599
APA StyleBillamboz, M., & Jawhara, S. (2023). Anti-Malassezia Drug Candidates Based on Virulence Factors of Malassezia-Associated Diseases. Microorganisms, 11(10), 2599. https://doi.org/10.3390/microorganisms11102599







